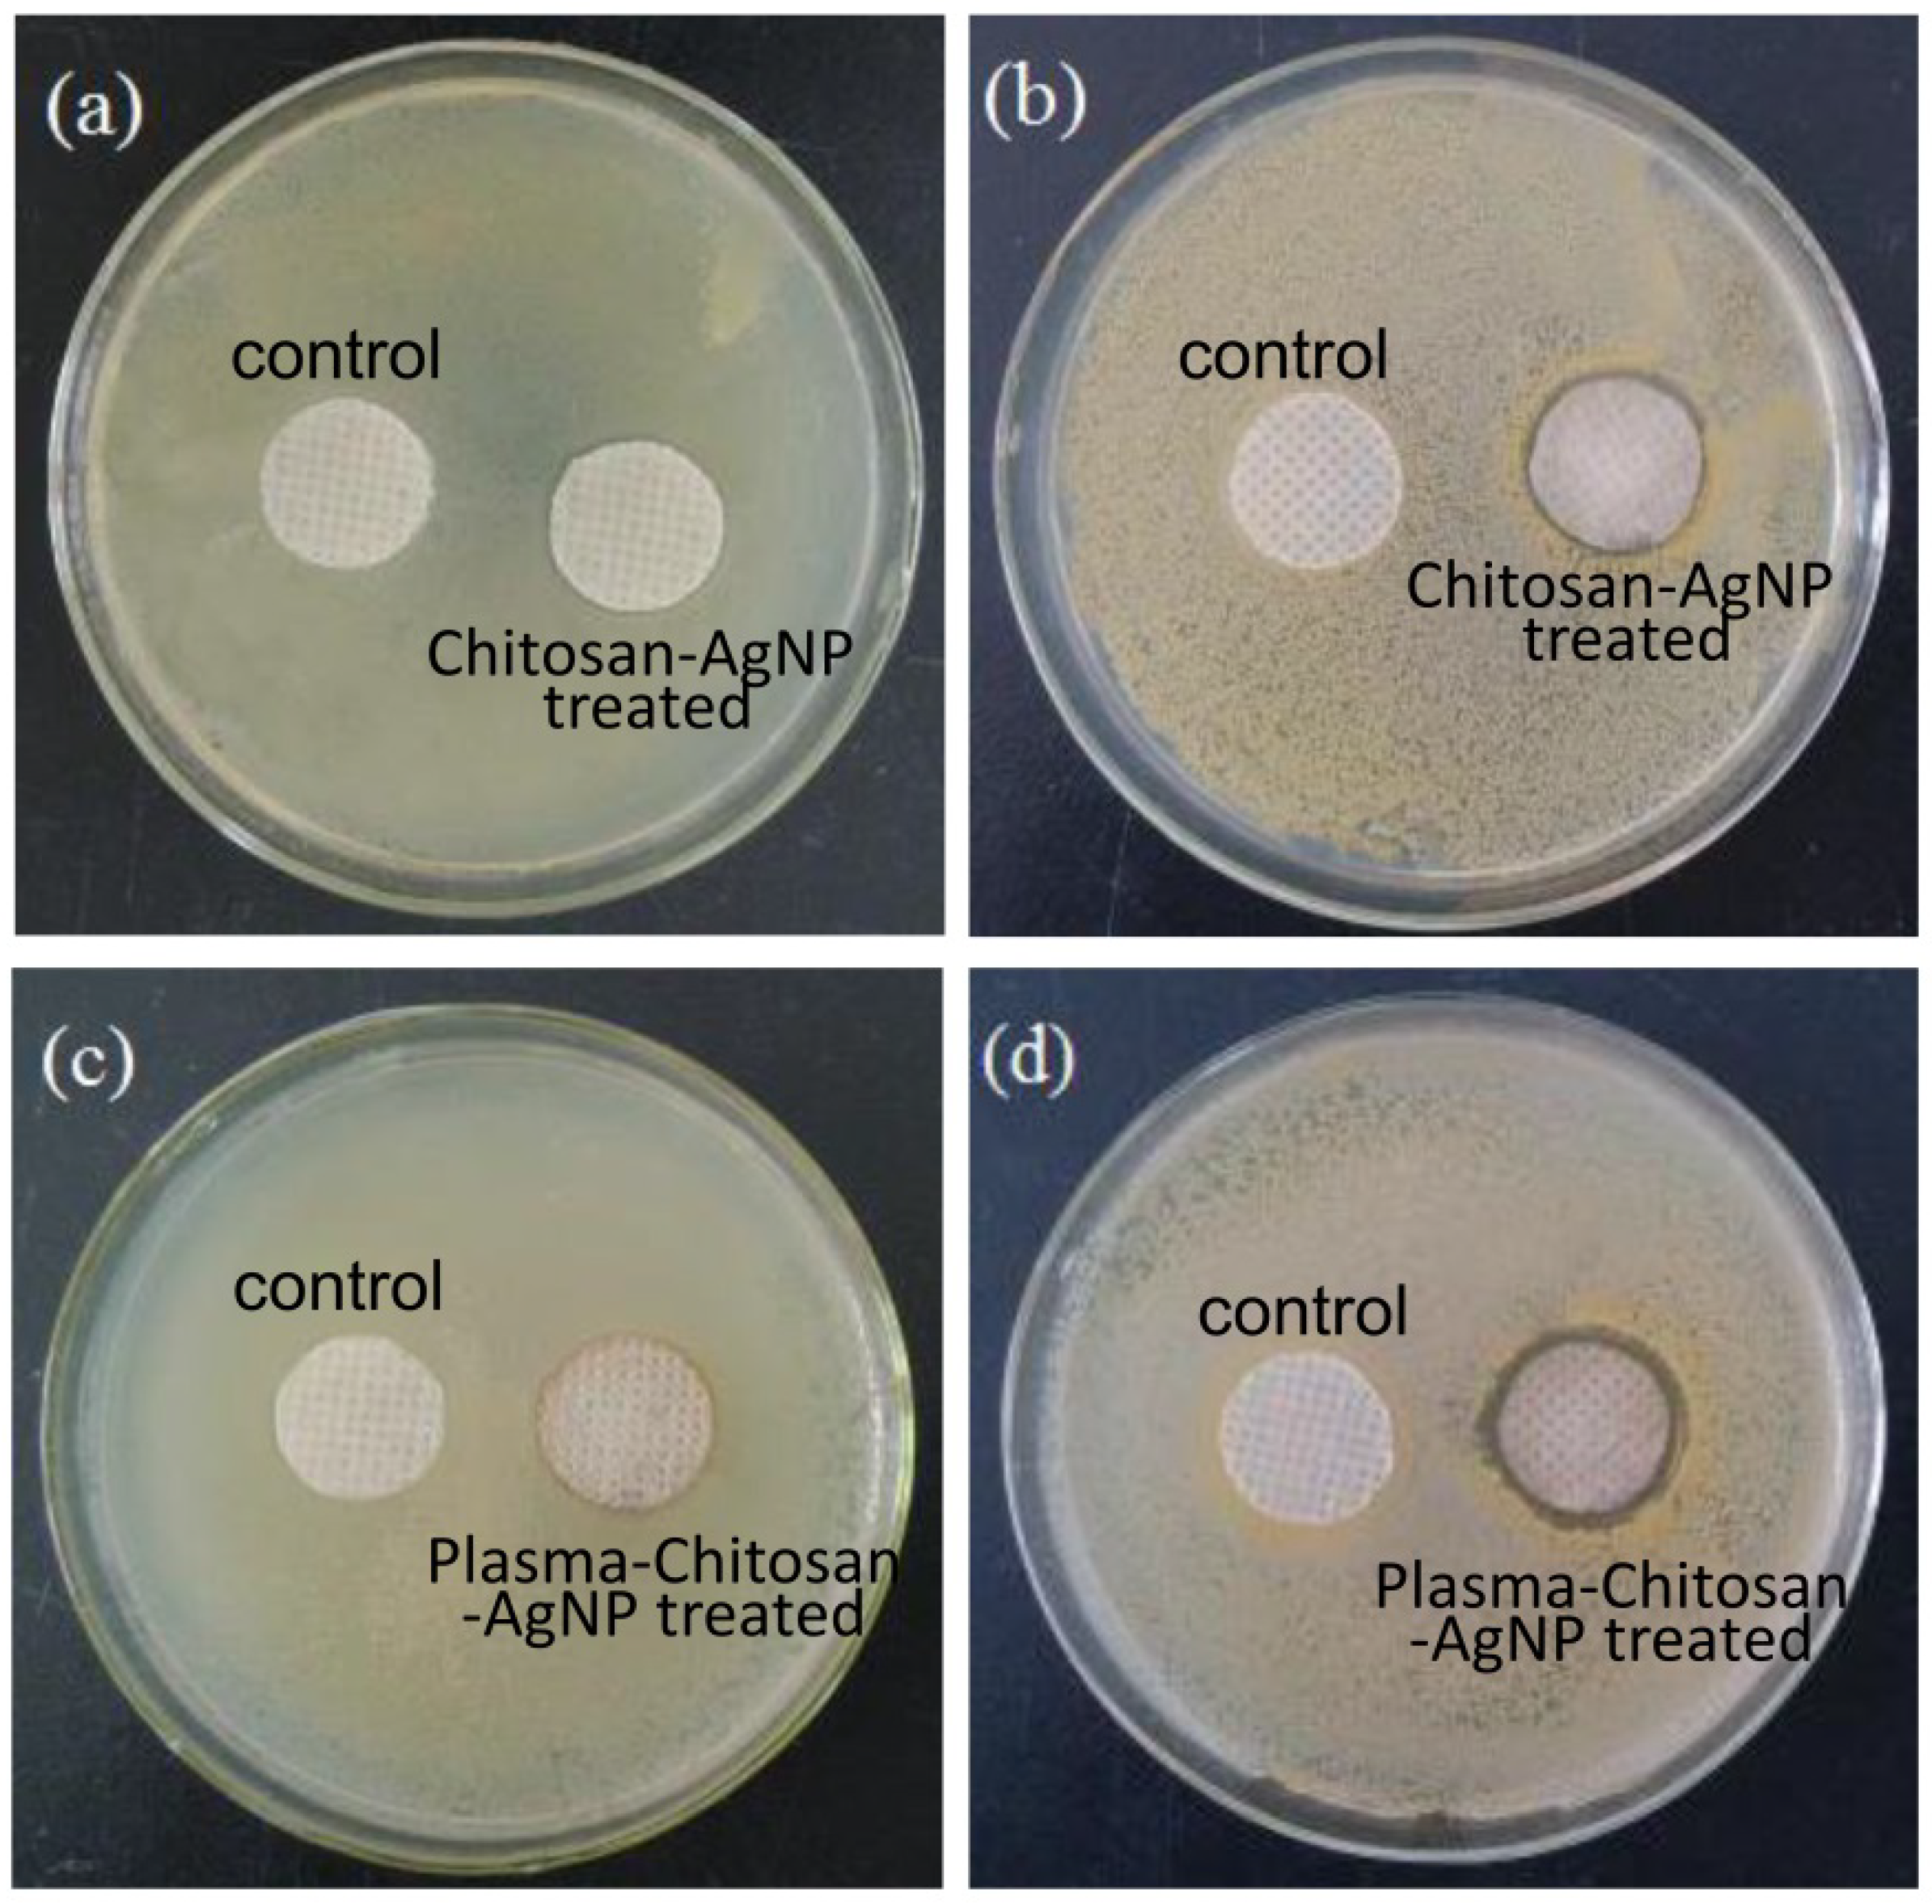
Coatings 11 01517 g008

In Situ Reduction of Silver Nanoparticles on the Plasma-Induced Chitosan Grafted Polylactic Acid Nonwoven Fabrics for Improvement of Antibacterial Activity
Abstract
:1. Introduction
2. Materials and Methods
2.1. Materials
2.2. Preparation of Chitosan Grafted PLA Nonwoven Fabrics
2.3. Preparation of Chitosan Grafted PLA/Ag NPs Nonwoven Fabrics
2.4. Surface Morphology Observation
2.5. Surface Chemical Composition Analysis
2.6. X-ray Diffraction (XRD) Pattern
2.7. Antibacterial Activity Test
3. Results and Discussion
3.1. Infrared Spectra
3.2. XRD Analysis
3.3. Surface Appearance and Morphology Analysis of PLA Based Nonwoven Fabrics
3.4. Analysis of Surface Chemical Composition
3.5. Antibacterial Activity
3.6. Mechanism of Silver Particles Absorption on PLA Nonwoven Fabrics
4. Conclusions
Author Contributions
Funding
Institutional Review Board Statement
Informed Consent Statement
Data Availability Statement
Conflicts of Interest
References
- Slepička, P.; Michaljaničová, I.; Kasálková, N.S.; Kolská, Z.; Rimpelová, S.; Ruml, T.; Švorčík, V. Poly-l—lactic acid modified by etching and grafting with gold nanoparticles. J. Mater. Sci. 2013, 48, 5871–5879. [Google Scholar] [CrossRef]
- Nampoothiri, K.M.; Nair, N.R.; John, R.P. An overview of the recent developments in polylactide (PLA) research. Bioresour. Technol. 2010, 101, 8493–8501. [Google Scholar] [CrossRef]
- Sui, L.; Zhang, B.S.; Wang, J.; Cai, A.N. Polymerization of PEDOT/PSS/chitosan-coated electrodes for electrochemical bio-sensing. Coatings 2017, 7, 96. [Google Scholar] [CrossRef] [Green Version]
- Murariu, M.; Dubois, P. PLA composites: From production to properties. Adv. Drug Deliv. Rev. 2016, 107, 17–46. [Google Scholar] [CrossRef]
- Armentano, I.; Bitinis, N.; Fortunati, E.; Mattioli, S.; Rescignano, N.; Verdejo, R.; Lopez-Manchado, M.A.; Kenny, J.M. Multifunctional nanostructured PLA materials for packaging and tissue engineering. Prog. Polym. Sci. 2013, 38, 1720–1747. [Google Scholar] [CrossRef] [Green Version]
- Manju, P.; Krishnan, P.S.G.; Kumar, N.S. Chemical modifications of PLA through copolymerization. Int. J. Polym. Anal. Charact. 2020, 25, 634–648. [Google Scholar] [CrossRef]
- MariaBeatrice, C.; Norma, M.; Sara, R.; Stefano, F.; Francesca, S.; Andrea, L. Compatibilization of poly(lactic acid) (PLA)/plasticized cellulose acetate extruded blends through the addition of reactively extruded comb copolymers. Molecules 2021, 26, 2006. [Google Scholar] [CrossRef]
- Melania, B.; Katarina, B.; Przemysław, K. Crosslinking of polylactide by high energy irradiation and photo-curing. Molecules 2020, 25, 4919. [Google Scholar] [CrossRef]
- Ren, Y.; Wang, C.; Qiu, Y. Influence of aramid fiber moisture regain during atmospheric plasma treatment on aging of treatment effects on surface wettability and bonding strength to epoxy. Appl. Surf. Sci. 2007, 253, 9283–9289. [Google Scholar] [CrossRef]
- Ren, Y.; Wang, C.; Qiu, Y. Aging of surface properties of ultra high modulus polyethylene fibers treated with He/O2 atmospheric pressure plasma jet. Surf. Coat. Technol. 2007, 202, 2670–2676. [Google Scholar] [CrossRef]
- Wang, C.X.; Ren, Y.; Lv, J.C.; Zhou, Q.Q.; Ma, Z.P.; Qi, Z.M.; Chen, J.Y.; Liu, G.L.; Gao, D.W.; Lu, Z.Q.; et al. In situ synthesis of silver nanoparticles on the cotton fabrics modified by plasma induced vapor phase graft polymerization of acrylic acid for durable multifunction. Appl. Surf. Sci. 2017, 396, 1840–1848. [Google Scholar] [CrossRef]
- Jelil, R.A. A review of low-temperature plasma treatment of textile materials. J. Mater. Sci. 2015, 50, 5913–5943. [Google Scholar] [CrossRef]
- Jordavilaplana, A.; Fombuena, V.; Garciagarcia, D.; Samper, M.D.; Sancheznacher, L. Surface modification of polylactic acid (PLA) by air atmospheric plasma treatment. Eur. Polym. J. 2014, 58, 23–33. [Google Scholar] [CrossRef]
- Salem, T.; Uhlmann, S.; Nitschke, M.; Calvimontes, A.; Hund, R.-D.; Simon, F. Modification of plasma pre-treated PET fabrics with poly-DADMAC and its surface activity towards acid dyes. Prog. Org. Coat. 2011, 72, 168–174. [Google Scholar] [CrossRef]
- Shahidi, S.; Ghoranneviss, M.; Wiener, J. Improving synthetic and natural dyeability of polyester fabrics by dielectric barrier discharge. J. Plast. Film Sheeting 2015, 31, 286–308. [Google Scholar] [CrossRef]
- Ren, Y.; Xu, L.; Wang, C.; Wang, X.; Ding, Z.; Chen, Y. Effect of dielectric barrier discharge treatment on surface nanostructure and wettability of polylactic acid (PLA) nonwoven fabrics. Appl. Surf. Sci. 2017, 426, 612–621. [Google Scholar] [CrossRef]
- Cheng, K.; Chang, C.; Yang, Y.; Liao, G.; Liu, C.; Wu, J. Enhancement of cell growth on honeycomb-structured polylactide surface using atmospheric-pressure plasma jet modification. Appl. Surf. Sci. 2017, 394, 534–542. [Google Scholar] [CrossRef]
- Sauerbier, P.; Köhler, R.; Renner, G.; Militz, H. Surface activation of polylactic acid-based wood-plastic composite by atmospheric pressure plasma treatment. Materials 2020, 13, 4673. [Google Scholar] [CrossRef]
- Kudryavtseva, V.; Stankevich, K.; Gudima, A.; Kibler, E.; Zhukov, Y.; Bolbasov, E.; Malashicheva, A.; Zhuravlev, M.; Riabov, V.; Liu, T.; et al. Atmospheric pressure plasma assisted immobilization of hyaluronic acid on tissue engineering PLA-based scaffolds and its effect on primary human macrophages. Mater. Des. 2017, 127, 261–271. [Google Scholar] [CrossRef]
- Khodadadi, B.; Bordbar, M.; Yeganeh-Faal, A.; Nasrollahzadeh, M. Green synthesis of Ag nanoparticles/clinoptilolite using Vaccinium macrocarpon fruit extract and its excellent catalytic activity for reduction of organic dyes. J. Alloys Compd. 2017, 719, 82–88. [Google Scholar] [CrossRef]
- Wan, C.; Jiao, Y.; Sun, Q.; Li, J. Preparation, characterization, and antibacterial properties of silver nanoparticles embedded into cellulose aerogels. Polym. Compos. 2016, 37, 1137–1142. [Google Scholar] [CrossRef]
- Sun, B.; Hua, B.; Ji, X.; Shi, Y.; Zhou, Z.; Wang, Q.; Zhu, M. Preparation of silver nanoparticles with hydrophobic surface and their polyester based nanocomposite fibres with excellent antibacterial properties. Mater. Res. Innov. 2014, 18, 869–874. [Google Scholar] [CrossRef]
- Jin, L.S.; Nyoung, H.D.; Ji-Hoi, M.; Wan-Kyu, K.; Bok, L.J.; Soo, B.M.; Woong, P.S.; Eun, K.J.; Hyun, L.D.; Eun-Cheol, K.; et al. Electrospun chitosan nanofibers with controlled levels of silver nanoparticles. Preparation, characterization and antibacterial activity. Carbohydr. Polym. 2014, 111, 530–537. [Google Scholar] [CrossRef]
- Yildiz, A.; Bayramol, D.V.; Atav, R.; Ağirgan, A.Ö.; Kurç, M.A.; Ergünay, U.; Mayer, C.; Hadimani, R.L. Synthesis and characterization of Fe3O4@Cs@Ag nanocomposite and its use in the production of magnetic and antibacterial nanofibrous membranes. Appl. Surf. Sci. 2020, 521, 146332. [Google Scholar] [CrossRef]
- Xu, Q.; Li, R.; Shen, L.; Xu, W.; Wang, J.; Jiang, Q.; Zhang, L.; Fu, F.; Fu, Y.; Liu, X. Enhancing the surface affinity with silver nano-particles for antibacterial cotton fabric by coating carboxymethyl chitosan and l-cysteine. Appl. Surf. Sci. 2019, 497, 143673. [Google Scholar] [CrossRef]
- El-Shishtawy, R.M.; Asiri, A.M.; Abdelwahed, N.A.M.; Al-Otaibi, M.M. In situ production of silver nanoparticle on cotton fabric and its antimicrobial evaluation. Cellulose 2011, 18, 75–82. [Google Scholar] [CrossRef]
- Yazdanshenas, M.E.; Shateri-Khalilabad, M. The effect of alkali pre-treatment on formation and adsorption of silver nanoparticles on cotton surface. Fibers Polym. 2012, 13, 1170–1178. [Google Scholar] [CrossRef]
- Xu, L.Y.; Lai, Y.L.; Liu, L.; Yang, L.L.; Guo, Y.; Chang, X.J.; Shi, J.J.; Zhang, R.Y.; Yu, J.Y. The effect of plasma electron temperature on the surface properties of super-hydrophobic cotton fabrics. Coatings 2020, 10, 160. [Google Scholar] [CrossRef] [Green Version]
- Montazer, M.; Malekzadeh, S.B. Electrospun antibacterial nylon nanofibers through in situ synthesis of nanosilver: Preparation and characteristics. J. Polym. Res. 2012, 19, 9980. [Google Scholar] [CrossRef]
- Aider, M. Chitosan application for active bio-based films production and potential in the food industry: Review. LWT-Food Sci. Technol. 2010, 43, 837–842. [Google Scholar] [CrossRef]
- Dai, J.M.; Luo, Y.; Nie, D.; Jin, J.H.; Yang, S.L.; Li, G.; Yang, Y.M.; Zhang, W. pH/photothermal dual-responsive drug delivery and synergistic chemo-photothermal therapy by novel porous carbon nanofibers. Chem. Eng. J. 2020, 397, 125402. [Google Scholar] [CrossRef]
- Alaswad, S.O.; Lakshmi, K.B.; Sudha, P.N.; Gomathi, T.; Arunachalam, P. Toxic heavy metal cadmium removal using chitosan and polypropylene based fiber composite. Int. J. Biol. Macromol. 2020, 164, 1809–1824. [Google Scholar] [CrossRef]
- Xufei, L.; Junzhi, S.; Yangli, C.; Yan, L.; Fang, L. Antibacterial properties of chitosan chloride-graphene oxide composites modified quartz sand filter media in water treatment. Int. J. Biol. Macromol. 2019, 121, 760–773. [Google Scholar] [CrossRef]
- Preethi, S.; Abarna, K.; Nithyasri, M.; Kishore, P.; Deepika, K.; Ranjithkumar, R.; Bhuvaneshwari, V.; Bharathi, D. Synthesis and characterization of chitosan/zinc oxide nanocomposite for antibacterial activity onto cotton fabrics and dye degradation applications. Int. J. Biol. Macromol. 2020, 164, 2779–2787. [Google Scholar] [CrossRef] [PubMed]
- Bajpai, S.K.; Thomas, V.; Bajpai, M. Novel strategy for synthesis of ZnO microparticles loaded cotton fabrics and investigation of their antibacterial properties. J. Eng. Fibers Fabr. 2011, 6, 73–81. [Google Scholar] [CrossRef] [Green Version]
- Ren, Y.; Ding, Z.; Wang, C.; Zang, C.; Zhang, Y.; Xu, L. Influence of DBD plasma pretreatment on the deposition of chitosan onto UHMWPE fiber surfaces for improvement of adhesion and dyeing properties. Appl. Surf. Sci. 2017, 396, 1571–1579. [Google Scholar] [CrossRef]
- Wei, D.; Dong, C.; Liu, J.; Zhang, Z.; Lu, Z. A novel cyclic polysiloxane linked by guanidyl groups used as flame retardant and antimicrobial agent on cotton fabrics. Fibers Polym. 2019, 20, 1340–1346. [Google Scholar] [CrossRef]
- Guangyu, Z.; Dao, W.; Jiawei, Y.; Yao, X.; Wenyan, G.; Chuanfeng, Z. Study on the photocatalytic and antibacterial properties of TiO2 nanoparticles-coated cotton fabrics. Materials 2019, 12, 2010. [Google Scholar] [CrossRef] [Green Version]
- Debnath, T.; Islam, M.S.; Hoque, S.; Haque, P.; Rahman, M.M. Preparation and characterization of chitosan grafted poly(lactic acid) films for biomedical composites. J. Polym. Eng. 2020, 40, 333–341. [Google Scholar] [CrossRef] [Green Version]
- Pandiyaraj, K.N.; Ferraria, A.M.; Rego, A.M.B.d.; Deshmukh, R.R.; Su, P.-G.; Halleluyah, J.M.; Halim, A.S. Low-pressure plasma enhanced immobilization of chitosan on low-density polyethylene for bio-medical applications. Appl. Surf. Sci. 2015, 328, 1–12. [Google Scholar] [CrossRef]
- Sutton, A.; Franc, G.; Kakkar, A. Silver metal nanoparticles: Facile dendrimer-assisted size-controlled synthesis and selective catalytic reduction of chloronitrobenzenes. J. Polym. Sci. Part A Polym. Chem. 2009, 47, 4482–4493. [Google Scholar] [CrossRef]
- Kaspar, T.C.; Droubay, T.; Chambers, S.A.; Bagus, P.S. Spectroscopic evidence for Ag (III) in highly oxidized silver films by X-ray photoelectron spectroscopy. J. Phys. Chem. C 2010, 114, 21562–21571. [Google Scholar] [CrossRef]
- Liao, Y.; Wang, Y.; Feng, X.; Wang, W.; Xu, F.; Zhang, L. Antibacterial surfaces through dopamine functionalization and silver nanoparticle immobilization. Mater. Chem. Phys. 2010, 121, 534–540. [Google Scholar] [CrossRef]
- Biswas, D.P.; O’Brien-Simpson, N.M.; Reynolds, E.C.; O’Connor, A.J.; Tran, P.A. Comparative study of novel in situ decorated porous chitosan-selenium scaffolds and porous chitosan-silver scaffolds towards antimicrobial wound dressing application. J. Colloid Interface Sci. 2018, 515, 78–91. [Google Scholar] [CrossRef]
- Murugadoss, A.; Chattopadhyay, A. A ‘green’ chitosan–silver nanoparticle composite as a heterogeneous as well asmicro-heterogeneous catalyst. Nanotechnology 2008, 19, 015603. [Google Scholar] [CrossRef] [PubMed]

| Samples | Chemical Composition (%) | |||
|---|---|---|---|---|
| C1s | O1s | N1s | Ag | |
| Original PLA (Control) | 62.18 | 37.82 | - | - |
| CS-Ag NPs treated | 68.55 | 24.08 | 6.97 | 0.41 |
| DBD-CS-Ag NPs treated | 64.16 | 28.9 | 3.04 | 3.91 |
| Samples | Strains | 24 h (CFU) | R% |
|---|---|---|---|
| Control | E. coli | 2.1 × 104 | - |
| S. aureus | 1.3 × 104 | - | |
| CS treated | E. coli | 1.6 × 104 | 23.8 |
| S. aureus | 0.8 × 104 | 30.7 | |
| DBD-CS treated | E. coli | 1.2 × 104 | 42.8 |
| S. aureus | 6.6 × 103 | 49.2 | |
| CS-Ag NPs treated | E. coli | 5.9 × 103 | 71.9 |
| S. aureus | 2.4 × 103 | 81.5 | |
| DBD-CS-Ag NPs treated | E. coli | <10 | 99.99 |
| S. aureus | <10 | 99.99 |
Publisher’s Note: MDPI stays neutral with regard to jurisdictional claims in published maps and institutional affiliations. |
© 2021 by the authors. Licensee MDPI, Basel, Switzerland. This article is an open access article distributed under the terms and conditions of the Creative Commons Attribution (CC BY) license (https://creativecommons.org/licenses/by/4.0/).
Share and Cite
Ren, Y.; Fan, T.; Wang, X.; Guan, Y.; Zhou, L.; Cui, L.; Li, M.; Zhang, G. In Situ Reduction of Silver Nanoparticles on the Plasma-Induced Chitosan Grafted Polylactic Acid Nonwoven Fabrics for Improvement of Antibacterial Activity. Coatings 2021, 11, 1517. https://doi.org/10.3390/coatings11121517
Ren Y, Fan T, Wang X, Guan Y, Zhou L, Cui L, Li M, Zhang G. In Situ Reduction of Silver Nanoparticles on the Plasma-Induced Chitosan Grafted Polylactic Acid Nonwoven Fabrics for Improvement of Antibacterial Activity. Coatings. 2021; 11(12):1517. https://doi.org/10.3390/coatings11121517
Chicago/Turabian StyleRen, Yu, Tingyue Fan, Xiaona Wang, Yongyin Guan, Long Zhou, Li Cui, Meixian Li, and Guangyu Zhang. 2021. "In Situ Reduction of Silver Nanoparticles on the Plasma-Induced Chitosan Grafted Polylactic Acid Nonwoven Fabrics for Improvement of Antibacterial Activity" Coatings 11, no. 12: 1517. https://doi.org/10.3390/coatings11121517
APA StyleRen, Y., Fan, T., Wang, X., Guan, Y., Zhou, L., Cui, L., Li, M., & Zhang, G. (2021). In Situ Reduction of Silver Nanoparticles on the Plasma-Induced Chitosan Grafted Polylactic Acid Nonwoven Fabrics for Improvement of Antibacterial Activity. Coatings, 11(12), 1517. https://doi.org/10.3390/coatings11121517







